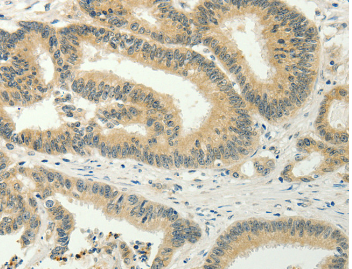

工作时间 :
周一~~周五
9:00 -18:00
在非工作时间,您可以通过邮件订购产品,订购时请写明详细联系方式,谢谢支持!
销售:18321282235
技术:021-60514606
传真:021-37680378
顾经理微信 扫一扫,关注我们
SPIN4 Polyclonal Antibody
货号:YBAP14657 |
|
![]() |
|
规格: 50ul/100ul/200ul |
|
价格: 980/1280/1890 |
|
| Immunogen: | Recombinant protein of human SPIN4 | ||
Synonym: |
|||
| Calculated MW: | |||
| Observed MW: | |||
Source: |
Rabbit | ||
Isotype: |
IgG | ||
Application: |
ELISA IHC | ||
Purify: |
Affinity purification | ||
Concentration: |
0.6mg/ml | ||
Storage Buffer: |
PBS with 0.05% sodium azide, 50% glycerol, pH7.3 | ||
Storage: |
Store at -20℃. Avoid freeze / thaw cycles. |
||
| Immunohistochemistry of Human liver cancer using SPIN4 Polyclonal Antibody at dilution of 1:20 |
Protocols: |
Buffer-Formulation WB-Guide IHC-Guide IP-Guide IF-Guide |
||
Background: |
This gene is a member of the SPINDLIN family. SPINDLIN was first reported as an abundant maternal transcript present in the unfertilized egg and 2-cell, but not the 8-cell, stage embryo during the transition from oocyte to embryo in the mouse. This family is involved in gametogenesis, and the expression of genes in this family can be detected in early embryos.
|
||
部门 |
姓名 | 手机 | |||
| 销售部 | 顾先生 | 1916510334@qq.com | 18321282235 | 1916510334 | |
| 技术部 | 技术支持 | 1781364813@qq.com | 13816899465 | 1781364813 |
全国免费电话:18321282235
销售: 18321282235
86-21-60514606
技术: 13816899465
传真: 021-37680378
The latest products